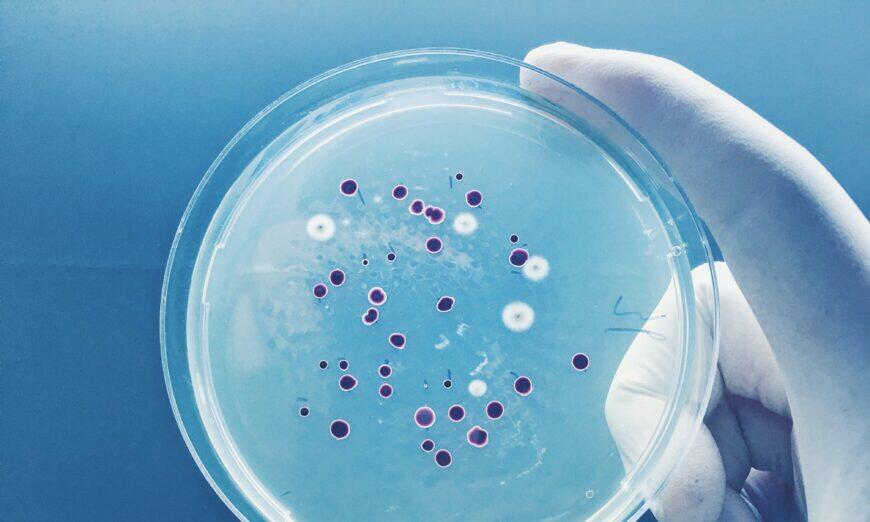

**All Hell Breaks Out In Chicago As Hundreds Of Teenagers Wreak Havoc**
All Hell Breaks Out In Chicago As Hundreds Of Teenagers Wreak Havoc
A trend of lawlessness has unfolded in cities run by progressive leaders this spring. The latest incident occurred on Saturday night in Downtown Chicago, where hundreds of teenagers wreaked havoc by smashing car windows and destroying public and private property. They also attempted to enter Millennium Park, which prompted a significant police response. There was even a shooting that resulted in multiple injuries.
FOX 32 Chicago (https://www.fox32chicago.com/news/hundreds-of-teenagers-flood-into-downtown-chicago-smashing-car-windows-and-prompting-police-response) reported massive crowds of teenagers that unleashed chaos in the downtown district last night. Besides the rogue kids smashing and breaking anything in their sight, there were reports of shots fired and two teenagers wounded by gunfire near the corner of Madison and Michigan.
Even FOX 32 said the chaos last night was "unsafe to keep our news crew on the scene." There was even footage of kids jumping on top of a bus.
 ?itok=yKv09zj_ (
?itok=yKv09zj_ ( ?itok=yKv09zj_)
?itok=yKv09zj_)
Watch the dramatic video of Chicago's youth 'gone wild.'
> 🚨#BREAKING (https://twitter.com/hashtag/BREAKING?src=hash&ref_src=twsrc%5Etfw): Chaotic Scene Unfolds in Downtown Chicago as Teenagers Vandalize Cars and Gunfire Erupts
>
> 📌#Chicago (https://twitter.com/hashtag/Chicago?src=hash&ref_src=twsrc%5Etfw) \| #Illinois (https://twitter.com/hashtag/Illinois?src=hash&ref_src=twsrc%5Etfw) ⁰
>
> There is currently a significant police response taking place in downtown Chicago due to a large group of teenagers causing chaos. They have been… pic.twitter.com/n7xhBpsTKs (https://t.co/n7xhBpsTKs)
>
> — R A W S A L E R T S (@rawsalerts) April 16, 2023 (https://twitter.com/rawsalerts/status/1647457314494971910?ref_src=twsrc%5Etfw)
> Cell phone video shows group jumping on vehicle along Michigan Avenue https://t.co/vyGYiYnHpp (https://t.co/vyGYiYnHpp)pic.twitter.com/gm00vZdwrO (https://t.co/gm00vZdwrO)
>
> — ABC 7 Chicago (@ABC7Chicago) April 16, 2023 (https://twitter.com/ABC7Chicago/status/1647460856505020416?ref_src=twsrc%5Etfw)
> Equity… Chicago pic.twitter.com/ucCdPw5DqW (https://t.co/ucCdPw5DqW)
>
> — @amuse (@amuse) April 16, 2023 (https://twitter.com/amuse/status/1647613431132872709?ref_src=twsrc%5Etfw)
"This is the second time this weekend that a group of rowdy teenagers has prompted a police response," the local media outlet pointed out.
The culture of lawlessness continues, and it's not even summer. The video is proof of the rapid moral decay of the younger generation that has been educated in failed liberal institutions.
Meanwhile, Chicago's new mayor, Brandon Johnson, is another soft-on-crime progressive who comes after Lori Lightfoot was ejected from office for failing to make the city safer.
Chicago is not the only city dealing with out-of-control youth. Another failed liberal city, Baltimore (https://www.zerohedge.com/political/baltimore-mayor-calls-citywide-curfew-after-all-hell-breaks-out), experienced similar chaos just one week ago.
> Just a late night run at the great Baltimore City’s #InnerHarbor (https://twitter.com/hashtag/InnerHarbor?src=hash&ref_src=twsrc%5Etfw)#SpringBreak (https://twitter.com/hashtag/SpringBreak?src=hash&ref_src=twsrc%5Etfw) vibes #SpringBreak2023 (https://twitter.com/hashtag/SpringBreak2023?src=hash&ref_src=twsrc%5Etfw)#Baltimore (https://twitter.com/hashtag/Baltimore?src=hash&ref_src=twsrc%5Etfw)#Maryland (https://twitter.com/hashtag/Maryland?src=hash&ref_src=twsrc%5Etfw)#น้องวินอยากเป็นพี่วิน (https://twitter.com/hashtag/%E0%B8%99%E0%B9%89%E0%B8%AD%E0%B8%87%E0%B8%A7%E0%B8%B4%E0%B8%99%E0%B8%AD%E0%B8%A2%E0%B8%B2%E0%B8%81%E0%B9%80%E0%B8%9B%E0%B9%87%E0%B8%99%E0%B8%9E%E0%B8%B5%E0%B9%88%E0%B8%A7%E0%B8%B4%E0%B8%99?src=hash&ref_src=twsrc%5Etfw)#TAEHYUNGxCELINE (https://twitter.com/hashtag/TAEHYUNGxCELINE?src=hash&ref_src=twsrc%5Etfw)#SuccessionHBO (https://twitter.com/hashtag/SuccessionHBO?src=hash&ref_src=twsrc%5Etfw)#Succession (https://twitter.com/hashtag/Succession?src=hash&ref_src=twsrc%5Etfw)#ChaguoSmartNaAirtel (https://twitter.com/hashtag/ChaguoSmartNaAirtel?src=hash&ref_src=twsrc%5Etfw)#Maryland (https://twitter.com/hashtag/Maryland?src=hash&ref_src=twsrc%5Etfw)#Taiwan (https://twitter.com/hashtag/Taiwan?src=hash&ref_src=twsrc%5Etfw)#TikTok (https://twitter.com/hashtag/TikTok?src=hash&ref_src=twsrc%5Etfw)#SummerMMFF2023 (https://twitter.com/hashtag/SummerMMFF2023?src=hash&ref_src=twsrc%5Etfw)#INVASION (https://twitter.com/hashtag/INVASION?src=hash&ref_src=twsrc%5Etfw)#Russia (https://twitter.com/hashtag/Russia?src=hash&ref_src=twsrc%5Etfw)… pic.twitter.com/X36btbT65g (htt…
https://www.zerohedge.com/political/all-hell-breaks-out-chicago-hundreds-teenagers-wreak-havoc
**Even ChatGPT Can Figure Out What Is Going On**
Even ChatGPT Can Figure Out What Is Going On
_By Eric Peters, CIO of One River Asset Management_
**Answers**
**“What happens when governments stifle innovation?”** I asked.
GPT4 answered: _"When governments stifle innovation, it can lead to reduced economic growth, decreased competitiveness, and a slower pace of technological advancement. Businesses may face regulatory barriers, restricted access to resources, and limited incentives for research and development. As a result, talented individuals might seek opportunities in more innovation-friendly environments, causing a brain drain and hindering the nation's progress."_
**“Why would governments ever stifle innovation?”**
GPT4 answered: " _Governments may inadvertently stifle innovation due to bureaucracy, excessive regulation, or protectionist policies aimed at preserving domestic industries. **They might also prioritize short-term political gains over long-term economic benefits, leading to misguided policies.** Additionally, some governments may lack the foresight to recognize the potential of new technologies or may act in response to pressure from special interest groups resistant to change."_
**“When governments stifle innovation, what is the best way to correct such mistakes?”**
GPT4 answered: _"It is crucial to identify and eliminate barriers to innovation, such as excessive regulations and bureaucracy. Governments should establish policies that incentivize research and development, invest in education, and promote collaboration between the public and private sectors. Encouraging open dialogue, fostering competition, and ensuring transparent and evidence-based decision-making can help create a more innovation-friendly environment."_
**“Why do governments avoid near-term pain, even if that amplifies longer-term costs?”**
GPT4 answered: _"Governments often prioritize near-term pain avoidance due to electoral cycles, political pressures, and the need for public support. Short-term benefits may secure votes or address immediate crises, even at the expense of long-term consequences. The complexity and uncertainty of long-term issues are challenging for policymakers. This short-termism can hinder the development of policies that serve society's broader interests in the long run."_
**“Why do individuals do the same?”**
GPT4 answered: " _Humans tend to avoid near-term pain due to cognitive biases and psychological factors. Present bias, for instance, makes immediate rewards and consequences appear more significant than future ones. Additionally, humans have difficulty accurately predicting long-term outcomes, leading to a focus on short-term gratification. Uncertainty, fear of failure, and aversion to change also contribute to this preference for avoiding short-term discomfort, even if it compromises long-term success."_
**Anecdote**
“Why are we so often our own worst enemies?” I asked myself. I didn’t bother asking GPT4, it couldn’t possibly give me the real answer. **We feed these large language models everything we’ve ever learned, which is why they tell us what we already know.** And this question remains as deep a mystery as any in the universe.
I first started to appreciate it as a young trader. The profession requires one to make frequent decisions, many of which are wrong. Both winning and losing trades can be cut short or left to run. And the profit/loss score card cannot be denied. In such a pursuit, each decision should be made coldly, rationally, with the sole objective to maximize profit while minimizing loss.
Yet there are times when traders act otherwise. We trade out of fear, greed, arrogance, stubbornness, narcissism, boredom, addiction. We add to losing longs in the irrational belief that by buying more, we may reverse a declining market. Or vice versa. We swear that if the market lets us get away with it one last time, we’ll never do it again. Sometimes a Hail Mary trade may work, even spectacularly.
And so reckless behavior is occasionally rewarded. But of course, in time, the market hunts down those unable to control their self-destructive impulses and ruins them. The ones who survive this battle with themselves learn to make decisions that are hard, humbling, and exploit the behavioral weaknesses and lack of discipline in others. Naturally, such elemental flaws manifest in every aspect of who we are; personally, professionally, politically. They are the source of the world’s infinite complexity, our pain, political dysfunction too.
It is why we must celebrate those rare dissenters with the courage to take a stand, forcing us to face our reflection when we succumb to our inner enemies. But these mysterious flaws are also the source of our sublime beauty. **If we optimized for cold rationality, we would be utterly boring algorithms. Perhaps like the AIs we are creating. Which I suspect will never fully appreciate us.**
Tyler Durden (ht…
https://www.zerohedge.com/markets/even-chatgpt-can-figure-out-what-going
**South Korea Fires Warning Shots At North Korean Patrol Boat That Breached Boundary**
South Korea Fires Warning Shots At North Korean Patrol Boat That Breached Boundary
A dangerous live-fire incident has been reported in a disputed sea border patrolled by both North and South Korea on Saturday.
Reportedly a North Korean vessel had been pursuing a Chinese fishing boat, according to the military statement, and subsequently **retreated after warning shots were fired from a South Korean military patrol boat**.
 ?itok=Vb8xv1HR\
?itok=Vb8xv1HR\
_Illustrative, via Reuters_ ( ?itok=Vb8xv1HR)
?itok=Vb8xv1HR)
"Our military maintains decisive battle posture while monitoring the enemy’s movements in preparation for potential provocations regarding NLL (Northern Limit Line) violations by North Korean patrol boats," the South Korean Joint Chiefs of Staff said in a Sunday Statement, confirming the prior day's incident.
Tensions are already soaring after a series of joint US-South Korea military drills which have been answered with the north conducting a series of major weapons tests, including of ballistic missiles and what's been described (https://www.cnn.com/2023/04/07/asia/north-korea-underwater-drone-nuclear-warhead-test-intl-hnk/index.html) as **an underwater nuclear drone**.
Saturday's incident on the seas may have involved a collision, as _The Hill_describes (https://thehill.com/policy/international/3953131-south-korea-warning-shots-fired-at-north-korean-patrol-boat-that-crossed-boundary/):
> _The disputed sea border between the two countries, the Northern Limit Line, has served as a theater for provocation and naval showdowns in the past. South Korean officials said one of its ships **came into "minor" contact with a Chinese vessel** due to poor visibility, but said there were only slight injuries reported._
As for Pyongyang's spate of recent missile tests, _Time_ has analyzed missile launch data by North Korea and compared it to last year's (https://time.com/6266737/north-korea-ballistic-missile-tests-2023/):
> _Last year was already record-breaking: data from the James Martin Center for Nonproliferation Studies, which has been documenting North Korean missile launches since 1984, showed 68 tests in 2022 (https://www.nti.org/analysis/articles/cns-north-korea-missile-test-database/)—10 times more than in 2021. And there are no signs that the country plans to let up._
Already the country is on track to surpass this:
> _On Thursday morning local time, prompting a temporary evacuate-or-seek-shelter warning in Japan, North Korea reportedly fired a ballistic missile toward the East Sea—Pyongyang’s **12th test of the year so far**, according to a review by TIME of reports by North Korea’s state news agency, South Korea’s military, and international media._
 ?itok=PQB8J2ZM (
?itok=PQB8J2ZM ( ?itok=PQB8J2ZM)
?itok=PQB8J2ZM)
Regional US ally Japan in particular has been fearful of the increasing tests ordered by the Kim Jong-Un regime. Upon a last Thursday launch, Japan issued an evacuation order for a northern island but soon retracted it when the missile's flight path was believed no longer a threat.
Tyler Durden (https://cms.zerohedge.com/users/tyler-durden)Sun, 04/16/2023 - 18:00
**The Empty Downtown - A New Normal?**
The Empty Downtown - A New Normal?
Three years after the coronavirus pandemic (https://www.statista.com/topics/6084/coronavirus-covid-19-in-the-us/) began, **the situation of North American downtowns remains fundamentally changed**.
_As Statista's Katharina Buchholz reports below_ (https://www.statista.com/chart/29722/cellphone-activity-in-north-american-downtowns/), while most people's lives have returned to normal, the legacies of the lockdown era continue to affect formerly bustling city centers to a point that could cause a downwards spiral.
 ?itok=mGdCkcav (
?itok=mGdCkcav ( ?itok=mGdCkcav)
?itok=mGdCkcav)
Data collected by the University of Toronto School of Cities (https://downtownrecovery.com/index.html) shows that as of the fall of 2022, **the downtowns of many major population centers in the U.S. (https://www.statista.com/topics/7313/metropolitan-areas-in-the-us/)and Canada were still recording much less activity than before the pandemic.** Los Angeles had gained back around two thirds of its former life (as measured by cellphone activity), but other downtowns - like in Chicago, Vancouver in British Columbia, Seattle and San Francisco - are now at most half as active as they had been before the pandemic. The lull also affects boomtowns of former years like Denver, Atlanta and Houston.
 (https://www.statista.com/chart/29722/cellphone-activity-in-north-american-downtowns/)
(https://www.statista.com/chart/29722/cellphone-activity-in-north-american-downtowns/)
_You will find more infographics at Statista (https://www.statista.com/chartoftheday/)_
According to reporting from the San Francisco Chronicle, (https://www.sfchronicle.com/podcasts/article/doom-loop-empty-downtown-17855041.php) at home in the most affected city in the analysis, **it all started with workers that did not return to downtown offices after the pandemic ebbed, instead preferring (and convincing their employers) to work fully remote, either from a cheaper suburb or from outside of any urban center.** This is causing vacant office blocks, decreasing ridership on public transport and less money spent on lunchtime or after-work activities, decreasing business revenue and in turn, the cities' tax income.
Arpit Gupta of the NYU Stern School of Business, who was interviewed by the Chronicle, said that this **could make downtowns appear even more unattractive as city services might have to be cut, empty transit could be seen as more dangerous and ultimately, the number of downtown amenities like shops and restaurants could decrease, prompting even more workers to wave goodbye to a certain city.** Hybrid work, however, has the power to keep tying workers to downtowns, but this normally requires high-quality office space. Another idea, according Gupta, is to draw people into city centers - as tenants or visitors - by focusing of livability factors and creating experiences that people crave.
**The American West coast has been hit especially hard by the phenomenon as its numerous tech companies pivoted to fully remote work more aggressively.** The University of Toronto data shows that apart from San Francisco, downtown activity has also stayed far below pre-pandemic levels in Portland, Ore. (37%), Seattle (44%) and Oakland, Calif (49%). Only four out of 62 analyzed downtowns surpassed their 2019 activity levels: Salt Lake City, Bakersfield and Fresno in California as well as El Paso, Texas.
Tyler Durden (https://cms.zerohedge.com/users/tyler-durden)Sun, 04/16/2023 - 13:00
https://www.zerohedge.com/covid-19/empty-downtown-new-normal
**What We Know About Jack Teixeira, Accused Of Involvement In Classified Documents Leak**
What We Know About Jack Teixeira, Accused Of Involvement In Classified Documents Leak
_Authored by Zachary Stieber and Jack Phillips via The Epoch Times (https://www.theepochtimes.com/what-we-know-about-jack-teixeira-accused-of-involvement-in-classified-documents-leak_5194429.html?utm_source=partner&utm_campaign=ZeroHedge&src_src=partner&src_cmp=ZeroHedge) (emphasis ours),_
 ?itok=RSF941ZY\
?itok=RSF941ZY\
_Jack Teixeira, in T-shirt and shorts, being taken into custody by armed tactical agents in Dighton, Mass., on April 13, 2023. (WCVB-TV via AP)_ ( ?itok=RSF941ZY)
?itok=RSF941ZY)
**A 21-year-old has been taken into custody (https://www.theepochtimes.com/fbi-agents-arrest-man-reportedly-identified-as-classified-document-leak_5192895.html) for allegedly being involved in the leak of secret U.S. military documents.**
Jack Teixeira of the Massachusetts Air National Guard was arrested on April 13 at a home in southern Massachusetts, about 18 miles east of Providence, Rhode Island.
Here’s what we know about Teixeira.
IT Specialist
**After enlisting in September 2019, Teixeira became a cyber transport systems specialist,** a National Guard spokesperson told The Epoch Times via email.
According to his specialty code, Teixeira was listed at the lowest skill level.
Describing cyber transport systems personnel, the Air Force website states: “A vast, global communications network is one of the many things that makes us the most powerful air force on the planet. Making sure the underlying infrastructure of this network is operating properly is the responsibility of Cyber Transport Systems specialists. Whether it’s repairing a network hub at a stateside base or installing fiber-optic cable at a forward installation overseas, these experts keep our communications systems up and running and play an integral role in our continuing success.”
The minimum education for a cyber transport systems role is a high school diploma or a general education diploma. Specialist requirements include knowledge of electronic and network principles; experience in the installation of voice, data, and video network infrastructure; and completion of basic military training.
**Teixeira has been mobilized for federal duty under Title 10 since 2021, according to the National Guard.**
**Teixeira was assigned to the 102nd Intelligence Wing,** which is based out of Otis Air National Guard Base.
“Our mission is to provide worldwide precision intelligence and command and control along with trained and experienced Airmen for expeditionary combat support and homeland security,” the wing’s website states.
**Teixeira had top secret clearance and sensitive compartmented access to other highly classified programs since 2021.**
Officials with the Massachusetts National Guard have not responded to requests for comment on Teixeira, who was awarded an Air Force Achievement Medal in September 2022.
 ?itok=9vv0aXUJ\
?itok=9vv0aXUJ\
_Jack Teixeira in a file image. (Instagram)_ ( ?itok=9vv0aXUJ)Took Documents Home
?itok=9vv0aXUJ)Took Documents Home
An investigation found that a person who had been posting the documents on social media initially transcribed text from the documents at work, but became concerned he would be discovered.
**The person, later identified as Teixeira, “began taking the documents to his residence and photographing them,”** charging documents stated (https://www.documentcloud.org/documents/23777132-teixeira-charging-document).
A social media user who spoke to the FBI said that the person called himself Jack, appeared to live in Massachusetts, and claimed he was in the U.S. Air National Guard.
The platform provided records to the FBI that included the billing name Jack Teixeira and a billing address for a residence in North Dighton, Massachusetts—the same home Teixeira listed as his residence in National Guard paperwork.
Discord, a social media platform on which some of the documents were posted, said it is cooperating with authorities.
As part of acquiring top secret clearance, **Teixeira would have signed a lifetime, binding non-disclosure agreement that acknowledged unauthorized disclosure of secret information could result in criminal charges.**
“This was a deliberate criminal act to violate those guidelines and rules,” Defense Department spokesman Air Force Brig. Gen. Pat Ryder told reporters as the arrest took place.
**Teixeira also held sensitive access to other classified programs.**
A document posted on the social media platform was accessible…
**Alaska Airlines Cancels Flights Due To Russian Volcano**
Alaska Airlines Cancels Flights Due To Russian Volcano
An giant ash cloud from a volcano in Eastern Russia has caused massive disruptions in air traffic into Alaska, and blanketed a Peninsula in Russia.
 ?itok=aKAbQmOe (
?itok=aKAbQmOe ( ?itok=aKAbQmOe)
?itok=aKAbQmOe)
Ash from the Shiveluch volcano on Russia’s Kamchatka Peninsula spewed as high as 20 kilometers (12.5 miles), according to Danila Chebrov, director of the Kamchatka branch of the Russian Academy of Sciences’ Geophysical Survey, _Reuters_ (https://www.reuters.com/world/europe/eruption-russias-kamchatka-threatens-aviation-response-team-2023-04-10/) reports. "The ash cloud moved westwards, and there was a very strong fall of ash on nearby villages."
As of 11 a.m. on Friday, Alaska Airlines had canceled 37 flights, bringing the week's total to 90 since Wednesday. The airline also warned that further cancellations were possible depending on where the ash cloud migrates.

?itok=RRWVb_rB)
The cloud is currently hanging over the Gulf of Alaska and the North Pacific Ocean, according to Nathan Eckstein, a science and operations officer at the Volcanic Ash Advisory Center in Anchorage, _Alaska Public (https://alaskapublic.org/2023/04/14/russia-volcano-disrupts-alaska-flights-for-third-day-in-a-row/)_ reports.
 ?itok=Iv6psX6q (
?itok=Iv6psX6q ( ?itok=Iv6psX6q)
?itok=Iv6psX6q)
"We have kind of a complicated system because this volcanic cloud is wrapped into a low that’s south of the Gulf of Alaska," he said. "Some parts of it have gone into British Columbia and the Yukon and Western Canada."
> _Tendrils of the volcanic cloud have even moved over Washington State. The cloud is made up of sulfur dioxide gas — and some ash. Eckstein says they’re analyzing images to see how the cloud is breaking up and where the pieces may move next. -Alaska Public_
"The ash is not going to stay suspended forever, it’s going to fall out, it’s going to get rained out if it’s underneath clouds that are precipitating," he continued.
Tyler Durden (https://cms.zerohedge.com/users/tyler-durden)Sun, 04/16/2023 - 12:00
https://www.zerohedge.com/weather/alaska-airlines-cancels-flights-due-russian-volcano
**California's Cautionary Clean Energy**
California's Cautionary Clean Energy
_Authored by Rea S. Hederman, Jr. & Will Swaim via RealClear Wire (https://www.realclearwire.com/articles/2023/04/13/californias_cautionary_clean_energy_893590.html),_
**California’s headlong rush to replace its electricity grid with renewable energy has given the rest of the country a preview of the decarbonized future** that President Biden and his revived Clean Power Plan envision for America. It isn’t pretty.
_
?itok=tZhbfb8d)_
Before supply-chain woes and federal stimulus goosed inflation, California’s cost of living already ranked (https://www.cnbc.com/2019/07/10/americas-10-most-expensive-states-to-live-in-2019.html) second highest in the nation. Enthusiastic efforts to rely more heavily on wind and solar power—touted as “cheap” sources of clean energy—have only made the state more expensive.
In 2015, President Obama imposed his Clean Power Plan to replace all coal-fired power plants with natural gas-fired plants and renewable energy. **California said, “hold my beer” and passed its own Clean Energy and Pollution Reduction Act** with even more ambitious decarbonization targets. To meet those targets, the state issued overzealous, poorly planned regulations that increased in-state electricity generation (https://www.energy.ca.gov/data-reports/energy-almanac/california-electricity-data/2021-total-system-electric-generation) from wind and solar farms by over twenty thousand gigawatt hours per year (https://www.energy.ca.gov/media/7311). Wind and solar power now account for a quarter of California’s energy supply.
**California and clean energy seem like a natural fit.** The state’s sunny coastlines, bright deserts, windy mountain passes, and deep river valleys should offer bountiful sources of cheap, all-natural solar, wind, and hydropower. Unfortunately, they don’t. Nightfall (https://www.energy.gov/eere/articles/confronting-duck-curve-how-address-over-generation-solar-energy), droughts (https://www.eia.gov/todayinenergy/detail.php?id=51839), and windless (https://fortune.com/2021/09/16/the-u-k-went-all-in-on-wind-power-never-imaging-it-would-one-day-stop-blowing/) days take these renewable power sources offline. And when intermittent clean energy sources cannot keep up with demand, California power providers turn to natural gas and electricity imports that backstop (https://www.latimes.com/california/story/2023-02-08/inadvertent-risk-exposure-high-natural-gas-prices-are-driving-cost-of-electricity-up) the state’s grid, but which are now more expensive due to the insufficient (https://timesofsandiego.com/politics/2023/02/12/california-utility-regulators-told-lack-of-storage-caused-spike-in-natural-gas-price/) storage and pipeline capacity created by the idealized rush to “cheap” clean energy.
Inefficient energy markets, unpredictable price spikes, unreliable power sources, and a hostile regulatory environment have all contributed to a 40 percent increase (https://www.bls.gov/regions/west/news-release/averageenergyprices_losangeles.htm) in the average California electric bill over the last five years. Retirees, low-income households, and middle-class families bear the brunt of the higher prices. **Millions of Californians now stretch their already strained budgets just to cover food, fuel, shelter, and an ever-rising electricity bill.**
President Biden’s new clean power proposal (https://www.whitehouse.gov/briefing-room/statements-releases/2021/04/22/fact-sheet-president-biden-sets-2030-greenhouse-gas-pollution-reduction-target-aimed-at-creating-good-paying-union-jobs-and-securing-u-s-leadership-on-clean-energy-technologies/) for a pollution-free power sector by 2035 threatens to make this California experience one that every state may soon enjoy. Under the president’s plan, natural gas has virtually no future in America. California and the rest of the country will be forced to replace natural gas power plants with renewable sources that will make electricity production unreliable and therefore more expensive.
California’s climate and geography make it more suited to a clean energy grid than any other state, but even California must rely on natural gas to keep the lights on. That does not bode well for Ohio and other cloudy states. According to the Farmer’s Almanac (https://www.farmersalmanac.com/top-10-cloudiest-u-s-states-22480), Ohio sees 63-77 sunny days per year. Michigan fares worse with only 65-75 clear days a year. California, on the other hand, sees the sun 146 days (https://www.currentresults.com/Weather/US/average-annual-state-sunshine.php) a year on average, second only to Arizona.
With half of California’s sunshine and no wind corridors near (https://eerscmap.usgs.gov/uswtdb/viewer/#3/37.25/-96.25)…
https://www.zerohedge.com/energy/californias-cautionary-clean-energy
**Sudan: All-Out War Erupts In Clash Of Rival Military Forces - Casualties Mount**
Sudan: All-Out War Erupts In Clash Of Rival Military Forces - Casualties Mount
**Smoldering tensions between rival armed forces erupted into all-out warfare in the Sudanese capital of Khartoum on Saturday, leaving at least 50 (https://www.bbc.com/news/world-africa-65284945) dead and 600 injured.** What began as a peaceful clash over Sudan's political future is now a war for control of Africa's third-largest (https://www.statista.com/statistics/1207844/largest-countries-in-africa-by-area/) country .
The battles pit **the Sudanese Armed Forces (SAF)** led by General Abdel Fattah al-Burhan against **the Rapid Support Forces (RSF)** of General Mohamed Hamdan Dagalo -- who's also known as Hemedti and has served as Burhan's deputy head of state.
 ?itok=-dAcYwz8 (
?itok=-dAcYwz8 ( ?itok=-dAcYwz8)via (
?itok=-dAcYwz8)via ( ?itok=-dAcYwz8)Britannica (https://www.britannica.com/place/Sudan)
?itok=-dAcYwz8)Britannica (https://www.britannica.com/place/Sudan)
**The two generals united in a 2021 coup to take shared control of the country**. However, recent months have seen mounting tensions between the SAF and RSF, as the generals have clashing positions in negotiations for the establishment of civilian government -- something the country's been trying to achieve since a 2019 revolution overthrew the 30-year reign of President Omar al-Bashir.
To say things have soured among the two former allies would be a major understatement: After fighting erupted, **Hemedti has reportedly (https://twitter.com/NesrineMalik/status/1647210334107713536?s=20) said that "Burhan will be captured or he will die like a dog."** Meanwhile, in a gesture that seems comically empty given the state of affairs, Burhan issued a decree commanding the RSF to disband (https://sputnikglobe.com/20230415/sudanese-army-chief-orders-rebel-militia-rapid-support-forces-to-disband-1109564077.html).
 ?itok=pA9xxJUn\
?itok=pA9xxJUn\
**Generals Dagalo aka Hemedti (left) and Burhan**(Mahmoud Hjaj/Anadolu Agency via AFP) ( ?itok=pA9xxJUn)
?itok=pA9xxJUn)
It's unclear who fired the first shot, but now **the two forces are battling for control of key Khartoum locations, including the presidential palace, army headquarters, state television and the airport**.
Battles have also been reported in various other cities. " **Large numbers of casualties reported in Nyala, South Darfur,"**tweeted (https://twitter.com/moehash1/status/1647253358384742400?s=20) BBC freelancer Mohanad Hashim. "We need to build a better picture of what is going on beyond Khartoum."
While _ZeroHedge_ can't authenticate them, videos are circulating on social media that purportedly show various scenes of combat. Here, a multiple-rocket launch system is deployed from the bed of a light truck, as other soldiers make a tardy exit from the backblast area:
> جانب من إشتباكات المدن.
>
> الله يحفظنا pic.twitter.com/Iv8fb5CVgT (https://t.co/Iv8fb5CVgT)
>
> — ملوك إشتباكات المواكب #رفاق\_الثورة (@Moshtabk) April 15, 2023 (https://twitter.com/Moshtabk/status/1647173270662262784?ref_src=twsrc%5Etfw)
**SAF jets were seen screeching low over the Khartoum skyline as they conducted airstrikes on RSF positions** in and around the city.
> Low-flying jets from Sudan Air Force over Khartoum. H/T to @amalhamdanelex (https://twitter.com/amalhamdanelex?ref_src=twsrc%5Etfw) for sharing.
>
> pic.twitter.com/F2OIzUJVbI (https://t.co/F2OIzUJVbI)
>
> — Benjamin Strick (@BenDoBrown) April 15, 2023 (https://twitter.com/BenDoBrown/status/1647198909452759041?ref_src=twsrc%5Etfw)
> Sudanese Air Force MiG-29 jet conducts airstrikes against RSF (Rapid Reaction/Support Forces) in Khartoum pic.twitter.com/AcrY3zhMBG (https://t.co/AcrY3zhMBG)
>
> — LogKa (@LogKa11) April 15, 2023 (https://twitter.com/LogKa11/status/1647270930870042624?ref_src=twsrc%5Etfw)
Some of the earliest fighting took place at Khartoum International Airport. Saudi Arabia's national airline, Saudia, reported one of its Airbus A330 jets had an "accident (https://www.businessinsider.com/saudi-airline-involved-accident-airport-khartoum-sudan-2023-4)." It was seen engulfed in flame, while **other videos showed multiple commercial aircraft ablaze**. All flights have been cancelled.
> BREAKING: Planes on fire at Khartoum airport after coup attempt in Sudan pic.twitter.com/aWdyMv23xs (https://t.co/aWdyMv23xs)
>
> — BNO News (@BNONews) April 15, 2023 (https://twitter.com/BNONews/status/1647185120313372673?ref_src=twsrc%5Etfw)
**Battles continued to rage overnight,** lighting up t…
**The Global Great Awokening**
The Global Great Awokening
_Authored by Noah Carl via The Daily Sceptic,_ (https://dailysceptic.org/2023/04/12/the-global-great-awokening/)
David Rozado has become something of a household name here at the _Daily Sceptic_, thanks to his pioneering studies on wokeness. You know those charts ( ) showing sharp upticks in the usage of terms like ‘sexism’, ‘racism’ and ‘transphobia’? He’s the guy who made them.
) showing sharp upticks in the usage of terms like ‘sexism’, ‘racism’ and ‘transphobia’? He’s the guy who made them.
 ?itok=BFnq7d-- (
?itok=BFnq7d-- ( ?itok=BFnq7d--)
?itok=BFnq7d--)
Until recently, he’d confined himself to studying the Anglosphere (https://dailysceptic.org/2022/10/17/scholarships-great-awokening/) and his native Spain (https://dailysceptic.org/2022/08/02/spains-great-awokening/). Rozado has now extended his analysis (https://davidrozado.substack.com/p/gag) to dozens of other countries, and what he finds is pretty remarkable: The Great Awokening is a _global_ phenomenon.
**In almost every country Rozado looked at, there was increase in the frequency of what he calls “prejudice-denoting terms” beginning around 2012.** As the left-hand chart below indicates, this was true even in countries like Kenya and Nigeria – where you’d assume people would be more concerned about things like poverty.
 ?itok=K5C7NSre (
?itok=K5C7NSre ( ?itok=K5C7NSre)
?itok=K5C7NSre)
_Charts taken from ‘The Great Awokening as a Global Phenomenon’._
The chart uses a standardised scale, which makes the trend in each country visible while masking average differences across countries. So what do those average differences show? When Rozado plotted them separately for each type of prejudice, the results were quite interesting (see right-hand chart above).
As you’d expect, mentions of ‘Islamophobia’ were most common in Muslim countries, while mentions of ‘anti-semitisim’ were by far the most common in Israel. And mentions of ‘sexism’ (and related terms) were most common in Spain. For the other three types of prejudice, the pattern was less clear, though the UK came close to the top on all three.
Perhaps the most interesting finding to emerge from Rozado’s analysis is that the big increase – **the “woke hockey stick”, as I’ve named it (https://dailysceptic.org/2022/10/17/scholarships-great-awokening/) – appears to be more or less simultaneous (https://twitter.com/DavidRozado/status/1644879512445001729) in all countries.** This is somewhat surprising. Most of us had been assuming that it occurred first in the US, then in other Western countries, and then (if at all) in the rest of the world.
Among Western countries, the US does (https://twitter.com/DavidRozado/status/1644879512445001729) appear to be a front-runner on mentions of ‘racism’, as you’d predict, though the margin isn’t huge. (Russia has also seen a big increase, though Rozado believes this mainly reflects commentary mocking the Western media’s preoccupations.)
**So _did_ the Great Awokening originate in America, as most of us had been assuming? I believe it did. Though I also believe it was amplified in many countries at the same time through social media.**
As to why the phenomenon probably _did_ originate in the US, you have to remember that non-Americans (https://en.wikipedia.org/wiki/List_of_countries_by_English-speaking_population#List) read American media far more than Americans read non-American media. What’s more, many influential journalists and activists in countries outside America go to study (https://archive.is/DTd9T) at America’s elite colleges, where they imbibe the tenets and language of woke ideology.
**So you’ve got many influential journalists and activists all around the world reading American media and regurgitating what they learned at US colleges.** Then social media hits. And because that’s where influential people congregate, articles couched in the latest woke jargon frequently go viral, causing less-influential people to adopt the same jargon in their own articles.
**Soon everyone in the media of a particular country is using terms like ‘patriarchy’, ‘transphobic’, and ‘people of colour’.**
My argument is admittedly somewhat speculative. But that doesn’t mean it can’t be tested. You’d have to go back and see which articles went viral first, and who wrote them. I suspect that English-speaking journalists, especially those who studied in America, would be overrepresente…
**The Disruptive Military Technologies The Pentagon Is Spending Nearly $150 Billion On**
The Disruptive Military Technologies The Pentagon Is Spending Nearly $150 Billion On
_Authored by John Haughey via The Epoch Times (https://www.theepochtimes.com/pentagon-officials-say-integrating-new-weapons-systems-can-cause-battlefield-disruption_5193557.html?utm_source=partner&utm_campaign=ZeroHedge&src_src=partner&src_cmp=ZeroHedge) (emphasis ours),_
President Joe Biden’s **$886.3 billion Fiscal Year 2024 (FY24) defense budget** request includes $145 billion for research and development into emerging technologies to create **new weapons systems using Artificial Intelligence (AI), hypersonic munitions, and electromagnetic swarms.**
 ?itok=Nr3zGrrP\
?itok=Nr3zGrrP\
_The U.S. Department of Defense launches a sounding rocket from NASA's launch range at Wallops Flight Facility on Wallops Island, Va., on Oct. 26, 2022. (Evelyn Hockstein/Reuters)_ ( ?itok=Nr3zGrrP)
?itok=Nr3zGrrP)
The Department of Defense (DOD) and its subsidiary military branch technology laboratories, working in tandem with universities and high-tech contractors that increasingly include small businesses, have produced such big-ticket splashes as newly deployed directed-energy weapons systems and hypersonic/ballistic sensors.
Among prospective products and systems seeking funding in the FY24 spending request is **a ‘Rocket Cargo’ transport that can move 100 tons of cargo anywhere on Earth within an hour;** a **counter-swarm electromagnetic weapon** that can disable drones and be powered from a wall plug; **a rotating detonation engine** without moving parts; a “pop-up hide” **that can make Marines disappear in plain sight**; a Predictive Vehicle Activity for Identification and Location (PreVAIL) program that “ **will bring a novel approach to automated target detection and recognition**.”
There are also less sexy utilitarian products being tested in the budget, such as a Portable Fluid Analyzer, a ship-to-ship system that converts Morse code into text messages, and an assembly line of bigger, faster, better-armed unmanned aircraft, from micro-drones to the latest Unmanned Long-endurance Tactical Reconnaissance Aircraft (ULTRA.)
**All have survived, or must soon traverse, “The Valley of Death.”**
Unlike notable valleys in American military history—Valley Forge, the Chosin, Khe Sanh, the Korengal—this “Valley of Death” is not a place on a map but that dreaded moment of realization on a military product development timeline when a cutting-edge weapon that will deliver a decisive battlefield advantage cannot advance out of prototype to production and get onto the battlefield in time.
 ?itok=IODm63Ym\
?itok=IODm63Ym\
_An operational version of the Active Denial System, a military counter-personnel directed energy weapon that is the equivalent of science fiction’s heat ray. (Unlisted USAF personnel/Public domain/ Wikimedia Commons )_ ( ?itok=IODm63Ym)‘The Valley of Death’
?itok=IODm63Ym)‘The Valley of Death’
Integrating new, still-maturing technologies into existing programs and platforms without “radical disruption” to multi-year procurement and acquisitions systems is among the most tweaky of challenges confronting the military, Pentagon officials said during a two-hour April 13 webinar presented by the National Defense Industrial Association (NDIA).
The DOD’s Under Secretary of Defense for Research & Engineering Heidi Shyu and the DOD’s Defense Advanced Research Projects Agency (DARPA) Director, Dr. Stefanie Tompkins, noted the proposed $145 billion Research, Development, Test, and Evaluation (RDT&E) budget is up 12 percent from this year with the Air Force receiving one-third of the requested outlay.
Shyu said the Science and Technology component of the RDT&E budget request is $17.8 billion, up 8.3 percent over this year’s $16.5 billion budget.
The annually updated National Defense Science & Technology Strategy is on Secretary of Defense Lloyd Austin’s desk, she said.
Shyu said the strategy will focus on joint mission; creation and deployment of capabilities at speed and scale; establishment of an enduring advantage in talent, infrastructure, research, and collaboration; directed energy weapons; and hypersonic/ballistic sensors.
Technology leaders for three military branches—Army Deputy Assistant Secretary for Research & Technology William Nelson, Naval Research Chief Rear Adm. Lorin Selby, Air Force Research Laboratory Commander Maj. Gen. Heather Pringle—outlined cooperative ventures with industry and workforce development plans, especially in currying bids a…
**Watch: Beyond The Reset**
Watch: Beyond The Reset
This excellent animated short film about the **not-too-distant-but-very-dystopian future** is at once humorous and terrifying.
 ?itok=yg7Ej7Ez (
?itok=yg7Ej7Ez ( ?itok=yg7Ej7Ez)
?itok=yg7Ej7Ez)
It speculates on the **potential consequences of the infamous Great Reset,** medical tyranny, woke culture, and green agenda.
 ?itok=TxdsgcKE (
?itok=TxdsgcKE ( ?itok=TxdsgcKE)
?itok=TxdsgcKE)
**Everything, that World Economic Forum (WEF) is planning for us.**
_If you'd like to buy the creator a beer, his PayPal address is oleg@3depix.com (mailto:oleg@3depix.com)_
Tyler Durden (https://cms.zerohedge.com/users/tyler-durden)Sat, 04/15/2023 - 23:00
**They Must Have A Good Reason**
They Must Have A Good Reason
_Authored by Todd Hayen via Off-Guardian.org,_ (https://off-guardian.org/2023/04/15/they-must-have-a-good-reason/)
**There is a strange idea hovering about that if you don’t know something then it doesn’t exist.**
 ?itok=P_bf3r9K (
?itok=P_bf3r9K ( ?itok=P_bf3r9K)
?itok=P_bf3r9K)
Kind of like the image of the proverbial ostrich with his head in the sand. **But it goes beyond denial. Ignorance is when you don’t know something at all, denial is when you know it, but you ignore it.**
What I am talking about here is when you know something and do not deny it, but simply rationalize it away with a statement like **_“they must have a good reason for doing that,”_ or similarly, _“maybe we don’t know all that there is to know about that.”_** Which is often followed with, _“and I don’t have the time, (inclination, care, interest, curiosity, ability, intelligence, etc.) to look into it further.”_
This has always bugged me to some extent, but I must admit I have been marginally guilty of this sort of thinking myself. I mean, do we really have the time to check everything? Well, now I think we have to make the time, and, of course, not everything is important enough to require vetting it for truth. That is an awful thing to say, but I am afraid it is the truth.
**Part of this “gullibility” that causes many people to just brush things off assuming that all is ok comes from indoctrination from an early age.** I grew up in a culture that seemed to be really obsessed with people’s safety—particularly the safety of children. Think of all the recalls of toys and such. If some toy comes out that has the slightest bit of uncertainty about how it might harm your child, it is pulled.
I should not say I “grew up” with this because most of the crap I played with as a kid would be considered a lethal weapon today—Lawn Darts, BB and pellet guns, Vac-U-Forms, chemistry sets, Easy Bake ovens (this was my sister’s toy, she was a little girl, I was a little boy—I tell you this for clarity). The “safety craze” didn’t really start until a decade or so later. I even remember some kid I knew got an “Atomic Energy Lab” toy that had actual uranium ore in the kit.
I would have died (literally) to get my hands on one of these.
Those were the days.
So over the decades, due to these recalls and safety concerns, we have developed a false sense of security. What regulation agency would bother to recall Lawn Darts but at the same time allow an unsafe vaccine to reach the unwilling arms of children? Well, toys are toys, vaccines are medicine. There ‘ya go.
**The government, and other regulatory agencies, know what’s right, right?**
Being born into a culture (US) that was known for its integrity, truthfulness, righteousness, and a penchant for character and goodness (ha, ha), no one would ever think that the CIA would have been actively trying to assassinate Fidel Castro, among others, for decades.
I remember first hearing a rumor about this when I was about 15. **_“No way,”_ I thought to myself. _“Assassinations are illegal! My country would never be involved in such a thing!”_** Especially attempting to murder a leader of a country that really was just minding their own business. At least so it seemed. (Today, when we hear of such things, we shrug our shoulders and say, _“They must know what they are doing.”_)
And what about Iran’s Mosaddegh? He was minding his own business overseeing the affairs of Iran as Prime Minister from 1951 to 1953. The US wasn’t happy with him for a number of reasons (primarily economic, like, for example, Mosaddegh wanted Iran to get a bigger share of oil profits that the US and UK were sucking out of his nation’s oil fields, imagine that! What audacity!). The CIA bopped him off as well—indirectly with a CIA created insurrection, which led to Mosaddegh’s imprisonment and more than likely contributed to his health issues, then he died). Sure there is detail here I am not presenting, but you get the picture.
**The US Government must have had a good reason.**
How about Obama’s drone war? Killing a whole whack of people, including children (I would say “women and children” but I might get in trouble for that).
**He must have had a good reason.**
Personally, I don’t think there is any “good” reason to kill children—even if as collateral damage or unintentionally.
I am presenting here only a few examples among thousands…more than we even know of course. And this is just government actions, what about pharmaceutical actions, or other medical actions? **They all must have good reasons.**
As a whole most people seem to think that atrocities cannot happen in the US (or Canada, or the UK, or…
https://www.zerohedge.com/political/they-must-have-good-reason
**US Criticizes China's Death Sentence Of 'Wrongfully Detained' American Citizen**
US Criticizes China's Death Sentence Of 'Wrongfully Detained' American Citizen
_Authored by Aldgra Fredly via The Epoch Times (https://www.theepochtimes.com/us-criticizes-chinas-death-sentence-of-wrongfully-detained-american-citizen_5193787.html?utm_source=partner&utm_campaign=ZeroHedge&src_src=partner&src_cmp=ZeroHedge) (emphasis ours),_
**The United States on Thursday expressed its “disappointment” over China’s decision to uphold a death sentence of an American man who had been “wrongfully detained” for over a decade** on drug-related charges.
 ?itok=MoVzHqR3\
?itok=MoVzHqR3\
_Texas resident Katherine Swidan holds a picture of her son Mark Swidan who has been held in China for a decade. (Courtesy of the Swidan family)_ ( ?itok=MoVzHqR3)
?itok=MoVzHqR3)
Mark Swidan, a Houston resident, was detained on Nov. 13, 2012, while on a business trip to China. He was accused of being a part of a network involved in the manufacturing and trafficking of drugs.
Swidan pleaded not guilty to all charges but was denied by the Jiangmen Intermediate Court, **which upheld his death sentence with a two-year suspended sentence,** according to the U.S. Department of State.
“We are disappointed by this decision and will continue to press for his immediate release and return to the United States,” Vedant Patel, a Department of State spokesman, said in a statement. (https://www.state.gov/mark-swidans-suspended-death-sentence/)
“U.S. officials have repeatedly expressed their concerns to senior PRC \[People’s Republic of China\] officials about Swidan’s treatment, medical care, and his inability to send or receive mail in a timely manner,” he added.
Patel said that President Joe Biden and Secretary of State Antony Blinken will “continue to remain personally focused” on the release of Swidan and other U.S. nationals who were “wrongfully detained” or held hostage around the world.
Lack of Evidence
Swidan was aged 37 at the time of his arrest. He was sentenced to death in 2018 despite a lack of evidence presented against him.
**No drugs were found on Swidan’s body or in his hotel room when he was arrested**, according to a report \[pdf\] (https://www.ohchr.org/sites/default/files/Documents/Issues/Detention/Opinions/Session86/A_HRC_WGAD_2019_72_AdvanceEditedVersion.pdf) released by the United Nations Working Group on Arbitrary Detention in 2020.
The prosecution failed to produce forensic or telecommunications evidence, such as emails, phone call records, or letters. His passport records showed that Swidan was not in China when the alleged offense occurred.
U.S. officials had previously called for his release. In February, Texas Republicans—including Sen. Ted Cruz, Sen. John Cornyn, and Congressman Michael Cloud—introduced a resolution (https://www.cruz.senate.gov/newsroom/press-releases/sen-cruz-texas-colleagues-introduce-resolution-calling-for-release-of-texan-mark-swidan-wrongfully-detained-in-china) demanding his release ahead of Blinken’s planned trip to Beijing.
“ **They’ve sentenced him to death on charges for which they have little to no evidence,** and I had been urging Tony Blinken when he was going to Beijing to raise Mark’s case and to make the case for Mark to be released,” Cruz said in a statement. (https://www.cruz.senate.gov/newsroom/press-releases/on-face-the-nation-sen-cruz-calls-for-mark-swidan-release-and-countering-chinese-espionage-and-dependency)
Blinken indefinitely postponed his visit after a suspected Chinese spy balloon was detected flying over the continental United States. A U.S. military jet later shot down the balloon on Feb. 4.
“Bringing Mark Swidan home to his family should be a top priority for this administration,” Cloud said. (https://www.cruz.senate.gov/newsroom/press-releases/sen-cruz-texas-colleagues-introduce-resolution-calling-for-release-of-texan-mark-swidan-wrongfully-detained-in-china) “Too many innocent Americans remain wrongfully imprisoned by authoritarian regimes who are happy to collect human lives as a capital for future political bargaining.”
‘Badly Mistreated’
According to the U.N. report, Swidan was “badly mistreated” while in detention and exposed to “poor sanitary conditions.” He was denied medical treatment and barred from communicating with his family or U.S. Consulates.
_Read more **here...** (https://www.theepochtimes.com/us-criticizes-chinas-death-sentence-of-wrongfully-detained-american-citizen_5193787.html?utm_source=partner&utm_campaign=ZeroHedge&src_src=partner&src_cmp=ZeroHedge)_
Tyler Durden (https://cms.zerohedge.com/users/tyler-durden)Sat, 04/15/2023 - 22:00
**Hacking Humanity: Transhumanism**
Hacking Humanity: Transhumanism
_Authored by Michael Rectenwald via The Mises Institute,_ (https://mises.org/wire/hacking-humanity-transhumanism)
The notion that the world can be replicated and replaced by a simulated reality says a great deal about the beliefs of those who promote the metaverse \[treated in the previous chapter\]. **The conception is materialist and mechanistic at base, the hallmarks of social engineering.** It represents the world as consisting of nothing but manipulable matter, or rather, of digital media mimicking matter. It suggests that human beings can be reduced to a material substratum and can be induced to accept a technological reproduction in lieu of reality. Further, it assumes that those who inhabit this simulacrum can be controlled by technocratic means. **Such a materialist, mechanistic, techno-determinist, and reductionist worldview is consistent with the transhumanist belief that humans themselves will soon be succeeded by a new transhuman species**, or humanity-plus (h+)—perhaps a genetically and AI-enhanced cyborg that will outstrip ordinary humans and make the latter virtually obsolete.
 ?itok=0c4J5n7U (
?itok=0c4J5n7U ( ?itok=0c4J5n7U)
?itok=0c4J5n7U)
**The term transhumanism was coined by Julian Huxley, the brother of the novelist Aldous Huxley** and the first director-general of the United Nations Educational, Scientific and Cultural Organization (UNESCO). In an essay entitled “Transhumanism,” published in the book _New Bottles for New Wine_ (1957), Huxley defined transhumanism as the self-transcendence of humanity:
> The human species can, if it wishes, transcend itself—not just sporadically, an individual here in one way, an individual there in another way, but in its entirety, as humanity. We need a name for this new belief. Perhaps transhumanism will serve: man remaining man, but transcending himself, by realizing new possibilities of and for his human nature.
**One question for transhumanism is indeed whether this transcendence will apply to the whole human species or rather for only a select part of it.** But Huxley gave some indication of how this human self-transcendence might occur: humanity would become “managing director of the biggest business of all, the business of evolution . . .” As the first epigraph to this Part makes clear, Julian Huxley was a proponent of eugenics. And he was the President of the British Eugenics Society. It was in his introduction of UNESCO, as the director-general that he suggested that eugenics, after the Nazi regime had given it such a bad name, should be rescued from opprobrium, “so that much that now is unthinkable may at least become thinkable.” As John Klyczek has noted, “In the wake of vehement public backlash against the atrocities of the Nazi eugenic Holocaust, Huxley’s eugenics proper was forced to go under-ground, repackaging itself in various crypto-eugenic disguises, one of which is ‘transhumanism.’” Transhumanism, Klyczek suggests, is “the scientific postulate that human evolution through biological-genetic selection has been largely superseded by a symbiotic evolution that cybernetically merges the human species with its own technological handiwork.”
Contemporary transhumanist enthusiasts, such as Simon Young, believe that humanity can take over where evolution has left us to create a new and improved species—either ourselves, or a successor to ourselves:
> _**We stand at a turning point in human evolution. We have cracked the genetic code; translated the Book of Life. We will soon possess the ability to become designers of our own evolution.**_
In “A History of Transhumanist Thought,” Nick Bostrom details the lineage of transhumanist thought from its prehistory to the present and shows how transhumanism became wedded to the fields of genomics, nanotechnology, and robotics (GNR), where robotics is inclusive of Artificial Intelligence (AI). It is the last of these fields that primarily concerns us here. The transhumanist project has since envisioned the transcendence of humanity via technological means. In the past thirty years, this technological transcendence has been figured as “the singularity.”
Vernor Vinge, the mathematician, computer scientist, and science fiction author introduced the notion of the technological singularity in 1993. The singularity, Vinge suggested, is the near-future point at which machine intelligence will presumably supersede human intelligence. Vinge boldly declared: _**“Within thirty years, we will have the technological means to create superhuman intelligence. Shortly after, the human era will be ended.”**_ Vinge predicted that the singularity would be reached no later than, you guessed it, 2030. The question Vinge addressed was whether, and if so, how, the …
https://www.zerohedge.com/technology/hacking-humanity-transhumanism
**Stunning Satellite Images Show Rare "Superbloom" Blanketing California's Hillsides**
Stunning Satellite Images Show Rare "Superbloom" Blanketing California's Hillsides
After a deluge of atmospheric rivers that dumped 78 trillion gallons of water on California, effectively ending a severe multi-year drought (https://www.zerohedge.com/weather/half-california-lifted-out-drought-flooding-now-concern-more-rain-looms) within several months, a rare superbloom has emerged in the state's southern region across hillsides, and it's even visible from space.
CBS News reported new photos via NASA's Landsat 9 satellite show a rare wildflower superbloom in Southern California after years of drought. The wet conditions spurred the germination of flower seeds all at once, leading to large swaths of land covered in various colors.
 ?itok=D5um7geS\
?itok=D5um7geS\
_Southern California's superbloom phenomenon. Source: NASA_ ( ?itok=D5um7geS)
?itok=D5um7geS)
Maxar Technologies also published satellite photos showing the hillside outside Palmdale covered in yellow and orange flowers.
 ?itok=VZt6H--H (
?itok=VZt6H--H ( ?itok=VZt6H--H)
?itok=VZt6H--H)
Another image shows a hillside covered in purple.
 ?itok=EgQtJbK8 (
?itok=EgQtJbK8 ( ?itok=EgQtJbK8)
?itok=EgQtJbK8)
And another shows hillsides covered in yellow.
 ?itok=1wGgLicD (
?itok=1wGgLicD ( ?itok=1wGgLicD)
?itok=1wGgLicD)
The rare desert botanical phenomenon has captured the attention of Southern California residents. Many have taken day trips to see the colorful hillsides.
Although severe drought conditions have largely subsided and wildflowers blanket the hillsides, this abundance of vegetation could potentially serve as fuel for fires when drought conditions reemerge.
Tyler Durden (https://cms.zerohedge.com/users/tyler-durden)Sat, 04/15/2023 - 21:00
**Contentious COVID-19 Drugs Are All Anti-Malarial: May Not Be A Coincidence**
Contentious COVID-19 Drugs Are All Anti-Malarial: May Not Be A Coincidence
_Authored by Marina Zhang via The Epoch Times (https://www.theepochtimes.com/health/contentious-covid-19-drugs-are-all-antimalarial-may-not-be-a-coincidence_5164443.html?utm_source=partner&utm_campaign=ZeroHedge&src_src=partner&src_cmp=ZeroHedge) (emphasis ours),_
The COVID-19 recommendations hydroxychloroquine, ivermectin, and now artemisinin (https://www.theepochtimes.com/the-first-choice-natural-alternative-to-ivermectin-expert_5151952.html) all have one thing in common: They are antimalarial drugs or have such properties.
Yet studies suggest that this may not be a mere coincidence; malaria and COVID-19 may be more similar than people may realize.
_ ?itok=Q-yE4F92 (
?itok=Q-yE4F92 ( ?itok=Q-yE4F92)_
?itok=Q-yE4F92)_
Malaria Versus COVID-19
From the outset, malaria and COVID-19 are very distinct diseases.
**Malaria is a parasitic disease**. An infection starts when an individual is bitten by a mosquito carrying a parasite from the Plasmodium genus. Upon infection, the parasite first goes to the liver and multiplies in liver cells. Then it migrates to the bloodstream, invades and proliferates in red blood cells, and causes these cells to expand and burst.
Common malaria symptoms such as fever, chills, and sweating occur during the blood-stage infection. Complications include anemia, and on rare occasions, cerebral malaria, liver failure, fluid buildup in the lungs, and acute respiratory distress syndrome.
**COVID-19, on the other hand, is a viral disease**. Infection occurs primarily through the inhalation of contaminated droplets. The virus invades the body through the nasal cavities, entering the upper and then lower respiratory tracts.
Inflammation of the lungs ensues as the body’s immune cells fight off the infection. The person’s oxygen levels start dropping as inflammation worsens in the advent of a cytokine storm, and the lungs become damaged. Some of the virus can also go into the bloodstream and invade other organs, causing systemic inflammation and damage.
Several Commonalities
While one mainly affects blood cells and the other primarily affects the lungs, both diseases are characterized (https://www.ncbi.nlm.nih.gov/pmc/articles/PMC9445119/) by a strong inflammatory response early in the infection, according to a 2022 paper in Frontiers in Immunology.
Symptoms-wise, both infections from malaria and COVID-19 can lead to fever, fatigue, shortness of breath, diarrhea, and muscle pain.
If inflammation is prolonged, the body will experience a significant increase in cytokines, and individuals can become severely injured or even die.
The two diseases are also similar in that they both sequester iron, use the same receptors in their pathogenesis, and even share similar structures in their proteins.
Iron Storage
Both the Plasmodium parasite (https://academic.oup.com/jid/article/199/1/151/918640) and the SARS-CoV-2 virus (https://www.ncbi.nlm.nih.gov/pmc/articles/PMC7169647/) require iron to proliferate. Therefore, both the parasite and the virus need to store iron inside the ferritin protein within infected cells. High or increased levels of ferritin are therefore an indication of severe disease and inflammation.
**Drugs that are capable of targeting iron storage or preventing proliferation may therefore be successful in treating both malaria and COVID-19.**
Similar Receptors
The angiotensin-converting enzyme 2 (ACE-2) receptor is involved in both malaria and COVID-19 infections.
In COVID-19, the virus binds to ACE-2 to invade cells. ACE-2 is ubiquitous within the human body, present within at the very least:
- Lungs
- Blood vessels
- Muscles
- The gut
- Nerves
- Stomach
- Heart
- Kidneys
- Pancreas
- Testes
- Uterus
Organs that have a high number of ACE-2 receptors are therefore at a higher risk of COVID-19 infection.
The significance of ACE-2 in malaria is uncertain. However, one study (https://www.ncbi.nlm.nih.gov/pmc/articles/PMC8107224/), as well as the one published in Frontiers in Immunology, showed that **people who have their ACE-2 receptors reduced due to genetic predispositions are more resistant to malaria.**
According to the Frontiers in Immunology study, malaria parasites use the CD147 receptors on red blood cells to gain entry into the cell. The COVID-19 virus also uses CD147 in the absence of ACE-2 receptors. CD147 has also been linked to the formation of blood clots (https://pubmed.ncbi.nlm.nih.gov/25280014/) in COVID-19 infections.
Therapeutics that can target CD147 and ACE-2 may be successful in treating both malaria and COVID-19.
Similar Protein Structures
Additionally, both pathogens sha…
**Have Internal-Combustion-Engine Vehicle Sales Already Peaked?**
Have Internal-Combustion-Engine Vehicle Sales Already Peaked?
Electric vehicle (EV) sales have grown rapidly over the past few years, but have they managed to make a dent in the global market?
To find out, Visual Capitalist's Marcus Lu visualized (https://www.visualcapitalist.com/combustion-vehicle-sales-peak/) data from BloombergNEF (https://www.bnnbloomberg.ca/carmakers-can-kiss-pre-pandemic-combustion-car-sales-goodbye-1.1893191#) that breaks down annual vehicle sales by three categories:
- Internal combustion (including traditional hybrids)
- Plug-in hybrids
- Battery electric
 ?itok=XD42_XRt (
?itok=XD42_XRt ( ?itok=XD42_XRt)
?itok=XD42_XRt)
From this, we can see that EVs are definitely building up market share. In fact, combustion vehicle sales appear to have peaked in 2017.
Growth in EV Market Share
The following table lists global EV sales, as well as their relative market share.
**Year****EV Sales****EV Market Share (%)**2013206,0000.22014320,0000.42015543,0000.62016791,0000.920171,262,0001.320182,082,0002.220192,276,0002.520203,244,0004.220216,768,0008.3202210,522,00013.0
_\*Includes plug-in hybrids. Source: EV Volumes_
We can see that EV sales really picked up steam around 2019. This is likely due to various government subsidies and a growing list of models to choose from.
EV ranges, once a major limiting factor, are also becoming less of a concern as battery technology (https://www.visualcapitalist.com/the-top-10-ev-battery-manufacturers-in-2022/) improves and more charging stations become available.
Will Combustion Vehicle Sales Stage a Comeback?
It seems unlikely that combustion vehicles will be able to reclaim much of their lost market share.
China, the world’s largest car market, is leading the world in terms of EV adoption. As of 2022, one in four new cars sold in the country is electric. The U.S. and EU are transitioning slower, but should catch up thanks to government subsidies and a planned phase-out of fossil fuel vehicles.
In the EU, the sale of new internal combustion vehicles will be banned by 2035. However, an exemption was recently made on behalf of Germany to allow the sale of cars that run on synthetic fuels.
In the U.S., the 13 states that adhere to California’s Zero Emissions Vehicle (ZEV) Program are aiming for 100% of cars sold in 2035 to be ZEVs. These states include California, Colorado, Connecticut, Maine, Maryland, Massachusetts, Minnesota, New Jersey, New York, Oregon, Rhode Island, Vermont, and Washington.
Tyler Durden (https://cms.zerohedge.com/users/tyler-durden)Sat, 04/15/2023 - 20:00
https://www.zerohedge.com/technology/have-internal-combustion-engine-vehicle-sales-already-peaked
**How AI Can Track, Manipulate Voters**
How AI Can Track, Manipulate Voters
_Authored by Kevin Stocklin via The Epoch Times (https://www.theepochtimes.com/how-ai-can-track-manipulate-voters_5180341.html?utm_source=partner&utm_campaign=ZeroHedge&src_src=partner&src_cmp=ZeroHedge) (emphasis ours),_
**How well do artificial intelligence (AI) programs know us humans?**
 ?itok=8BaADUZc\
?itok=8BaADUZc\
_A visitor watches an AI (Artificial Intelligence) sign on an animated screen at the Mobile World Congress (MWC), the telecom industry's biggest annual gathering, in Barcelona. (Josep Lago/AFP via Getty Images)_ ( ?itok=8BaADUZc)
?itok=8BaADUZc)
In most cases, it’s quite well and, in some ways better than we know ourselves.
A study by AI experts at Brigham Young University, titled “Out of One, Many: Using Language Models to Simulate Human Samples (https://www.cambridge.org/core/services/aop-cambridge-core/content/view/035D7C8A55B237942FB6DBAD7CAA4E49/S1047198723000025a.pdf/out-of-one-many-using-language-models-to-simulate-human-samples.pdf),” found that predictive AI programs exhibited a striking degree of what they call “algorithmic fidelity,” or precise mapping to actual human behavior.
“Because these AI tools are basically trained on stuff that humans produce, **things that we write, documents we make, websites we write, they can reflect back to us a lot of interesting and important things about ourselves**,” Ethan Busby, political psychologist and co-author of the study, told The Epoch Times. “Kind of like if someone read your diary from start to finish, they would know a lot of things about you, and you’re not going to like every single thing.
“In a similar way,” Busby said, “these tools have read so many things that humans have produced, and they can replicate or say back to us things about ourselves that we didn’t necessarily know.”
The study sought to analyze human behavior in the context of elections and asked how accurately a GPT-3 language model could predict voting patterns based on socio-demographic factors like a person’s gender, age, location, religion, race, and economic status. The authors used these factors to create “silicon samples,” or composite personas based on varying combinations of these attributes.
“ **You can basically ask these tools to put themselves in a specific frame of mind and pretend to be essentially this person, pretend to have these characteristics**,” Busby said. They asked the program how these “silicon samples” would vote in specific campaigns, then they compared the results to actual voters’ behavior in elections between 2012 and 2020, using data from the American National Elections (https://electionstudies.org) studies.
For example, Busby said, regarding the 2016 election, “We could say what kinds of groups are going to be pivotal in Ohio?” What they found was that AI quickly learned to accurately predict how people would vote, based on their attributes.
Left and Right Decry AI, When It Costs Elections
Artificial intelligence is highly useful to organizations that want to target things like political messaging campaigns or fundraising efforts. But some political analysts have raised red flags about this, inferring unfairness and election interference. Their degree of outrage, however, largely depends on whether their candidates or causes succeeded or failed.
In 2017, The Guardian, a left-wing British newspaper, wrote a series of articles claiming that conservative tech entrepreneur Robert Mercer, whom it called “the big data billionaire waging war on the mainstream media (https://www.theguardian.com/politics/2017/feb/26/robert-mercer-breitbart-war-on-media-steve-bannon-donald-trump-nigel-farage),” had financed a campaign strategy using AI to circumvent mainstream media narratives. This, the paper alleged, illicitly swayed voters in favor of Donald Trump, resulting in his victory in the presidential election in 2016.
_Read more **here...** (https://www.theepochtimes.com/how-ai-can-track-manipulate-voters_5180341.html?utm_source=partner&utm_campaign=ZeroHedge&src_src=partner&src_cmp=ZeroHedge)_
Tyler Durden (https://cms.zerohedge.com/users/tyler-durden)Sat, 04/15/2023 - 19:30
https://www.zerohedge.com/political/how-ai-can-track-manipulate-voters
**Data-Centers & Small Nuclear Reactors - A Match Made In Heaven?**
Data-Centers & Small Nuclear Reactors - A Match Made In Heaven?
_Authored by Brian Gitt via RealClear Wire (https://www.realclearwire.com/articles/2023/04/12/onsite_nuclear_provides_247_clean_power_893420.html),_
**Most of us don’t think about the huge data centers that enable our constant internet usage.** But they’re essential to our civilization—and they consume enormous amounts of electricity 24/7.
 ?itok=nzqQWrT5 (
?itok=nzqQWrT5 ( ?itok=nzqQWrT5)
?itok=nzqQWrT5)
**Powering these data centers is fast becoming a problem**. Northern Virginia, for instance, hosts the largest concentration of data centers in the world. Tech giants like Amazon, Facebook, Microsoft, and Google have invested $126 billion (https://www.datacenterknowledge.com/colocation/report-data-centers-virginia-supported-17-billion-economic-output-2021) in Virginia data centers. And the region’s insatiable appetite for power continues to grow due to surging demand for cloud computing services.
**Without reliable power, cloud service providers can’t grow to match the pace of increasing demand. But the electrical grid can’t keep up.** Right now, power transmission bottlenecks in Northern Virginia could delay new data center development into 2026 (https://www.datacenterdynamics.com/en/news/dominion-energy-admits-it-cant-meet-data-center-power-demands-in-virginia/).
Data center developers across the pond are facing the same problem. Microsoft and Amazon halted plans to build new data centers in Dublin, Ireland, because of power shortages and threats of rolling blackouts. And British officials paused construction (https://www.datacenterdynamics.com/en/news/report-home-building-to-halt-in-west-london-due-to-data-center-power-demands/) on new houses in West London until 2035 because data centers had already maxed out the local grid’s capacity.
And it’s not just power consumption that is sparking opposition to data centers. Concerns about greenhouse gas emissions, water usage, noise pollution, and the overall sustainability of data centers are fueling local opposition that is constraining where—or even whether—data centers get built.
**Google, Amazon, Microsoft, and Facebook have responded to the demand for clean energy by investing heavily in wind and solar projects.** But wind and solar alone can’t solve the problem. Those energy sources simply can’t deliver the uptime that data centers need. Consider the European wind drought of 2021 that cut wind power in the UK by 32 percent for 6 months (https://www.cnbc.com/2021/09/29/sse-says-low-wind-dry-conditions-hit-renewable-energy-generation.html). The need for round-the-clock uptime presents a serious—perhaps insurmountable—obstacle to data centers relying solely on sources of power like wind and solar that don’t generate power at night, or on cloudy days, or when the wind doesn’t blow.
Some people hope we’ll eventually be able to store surplus wind and solar energy in batteries. But the reality is that batteries are too expensive to store enough energy to supply reliable power for weeks (let alone months) of uncooperative weather.
**The good news is that there’s a solution—a power source reliable enough to provide uptime round-the-clock at low cost and with zero emissions: a small onsite nuclear power plant dedicated to supplying power to a data center.**
Small modular reactors (SMRs) supply between 10 and 300 MW of power 24/7. A data center supplied by an SMR would face no more competition for power with local communities. No more waiting for new transmission lines or power plants to be built. And no more emissions. When we consider the full lifecycle of different power sources (including mining, manufacturing, and disposal), solar emits four times more carbon than SMRs.
SMRs differ from large conventional nuclear plants as much as modern smartphones differ from old rotary phones. Conventional plants are large and complicated, and cumbersome US and European regulations make them expensive to build. Two units (1,117 MWs each) currently being built in the US state of Georgia have cost upwards of $30 billion. Construction on them, moreover, is six years behind schedule, and when they finally come online in 2023, they will have taken 14 years to complete. These kinds of costs and delays present a capital risk factor for large conventional nuclear plants.
**Large nuclear reactors are also land-intensive.** They typically require over 800 acres and usually need to be sited near a lake, river, or the ocean to access water for cooling. Plus, they don’t recycle spent fuel.
SMRs are simpler and much less expensive to construct. **Off-the-shelf components and factory prefabrication bring construction costs as low as $60 million**…
https://www.zerohedge.com/energy/onsite-nuclear-provides-247-clean-power
**The E. Coli Super-Pathogens You Should Know About**
The E. Coli Super-Pathogens You Should Know About
_Authored by Dr. Sean Lin and Jacky Guan via The Epoch Times (https://www.theepochtimes.com/health/the-e-coli-super-pathogens-you-should-know-about_5175216.html) (emphasis ours),_
Foodborne illnesses, also known as food poisoning, are a serious public health issue (https://www.fda.gov/news-events/public-health-focus/e-coli-and-foodborne-illness). **Each year, they make 48 million people get sick, hospitalize 128,000, and cause the death of 3,000.** Pathogenic E. coli is one of the most common known foodborne pathogens. However, the severity of various E. coli strains varies tremendously and the public should be cautious about one particularly dangerous type of E. coli.
_ ?itok=x68bp-pZ (
?itok=x68bp-pZ ( ?itok=x68bp-pZ)_
?itok=x68bp-pZ)_
E. Coli 101
Escherichia coli, also known as E. coli, is one of the most common types of bacteria known to mankind. **From helping with digestion in your stomach to being a producer of artificial insulin, the bacteria discovered in 1885 have been studied countless times and improved our understanding of the microscopic world.**
The E. coli we infamously know from the news belong to the group Enteropathogenic E. coli (EPEC) and are pathogens responsible for food poisoning. Foodborne illnesses also include Salmonella and Norovirus (responsible for the recent cruise ship outbreaks). Typically, an E. coli infection occurs when a person comes into contact with contaminated food, animals, or water. It usually only causes mild abdominal pain or brief diarrhea. Other symptoms include stomach cramps, nausea, vomiting, and fever.
Typical treatment usually involves rest, hydration, and nutritional support. The disease is usually self-limiting as the body can normally clear it. The use of antibiotics is common in treating E. coli, yet antibiotic resistance is also a problem worldwide. However, severe forms of E. coli are the Shiga toxin-producing variants of the bacteria that can have dire consequences.
STEC Variants Severely Damage Intestinal Linings and Kidneys
The variants of E. coli that produce Shiga toxins (Stx) are called Shiga **toxin-producing E. coli, or STEC.** They have gained a lot of attention in the past few decades, as they are known for causing severe disease.
STEC belongs to the EPEC group. STEC strains are capable of producing toxins named Shiga toxin type 1 (Stx1), type 2 (Stx2), or both, encoded by stx1 and stx2 genes, respectively.
The toxins are named after Kiyoshi Shiga, who first described the bacterial origin of dysentery caused by Shigella dysenteriae. Historically, the toxin produced by E. coli was named Shiga-like toxin (SLT). Now, Shigella dysenteriae and STEC are regarded as the most common sources of Shiga toxins.
Symptoms of a STEC infection include abdominal pain and watery diarrhea. **There are also severe—possibly life-threatening—cases characterized by hemorrhagic colitis**. These types of E. coli are also called Enterohemorrhagic E. coli (EHEC). Shiga toxins are also associated with hemolytic uremic syndrome (HUS).
In particular, the STEC O157:H7 and STEC O104:H4 are the two most notorious STEC strains. One could say these STEC groups are something like super soldiers in the E. coli army.
 ?itok=HnWrOCdW\
?itok=HnWrOCdW\
_Shiga toxin-producing bacteria are E. coli strains one does not want to encounter. (The Epoch Times)_ ( ?itok=HnWrOCdW)
?itok=HnWrOCdW)
The Shiga toxin does most of its work in small blood vessels, as it is rather ineffective in large vessels such as major veins and arteries. This is how the toxin can specialize against the digestive tract, kidney, and lungs. For example, the Shiga toxins are good at destroying clusters of nerve endings or small blood vessels in the kidneys, which can lead to kidney failure and even HUS. It can severely damage the lungs as well, so food poisoning associated with Shiga toxins is often also associated with lung and nervous system damage.
_Read more **here...** (https://www.theepochtimes.com/health/the-e-coli-super-pathogens-you-should-know-about_5175216.html)_
Tyler Durden (https://cms.zerohedge.com/users/tyler-durden)Sat, 04/15/2023 - 18:30
https://www.zerohedge.com/medical/e-coli-super-pathogens-you-should-know-about
